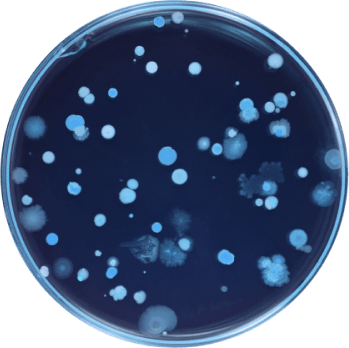

NEED-TO-KNOWS
Formulated for benefits in and beyond the gut.
5g of prebiotic fiber per serving.
No observed side effects or GI distress.
Engineered to survive digestion.
No refrigeration necessary.
Designed with
how-do-I-get-my-kid-to-take-this-dailyin mind.
in mind.
Evidence-based Benefits
Composition-specific Benefits
PDS-08® is the first 9-strain pediatric synbiotic to be studied in a double-blind, randomized 12-week trial in a pediatric population, demonstrating that it is tolerable and health-promoting for children and adolescents. The following benefits were observed in the composition as a whole:
Strain-specific Benefits
In addition to conducting a trial on the PDS-08® formulation as a whole, all strains included have been independently studied in clinical trials for efficacy and tolerability in a pediatric population.
Bridges thefiber gap.
Fiber is one of the hardest nutrients to incorporate into a child's diet—it can also directly impact the health of the gut microbiome.
95% of children and adults in the US do not reach theirdaily recommended fiber intake.
With 5 grams of fiber per serving, PDS-08® is a meaningful complement to a healthy diet.
Formulation
20.0 Billion AFU
6g molecular weighted inulin + FOS
No refrigeration required.
Gastrointestinal Immunity/Health Blend º
Gastrointestinal Immunity/Health Blend º
Lacticaseibacillus rhamnosusSD-GG-IT
Lactobacillus acidophilusSD-NCFM-US
Bifidobacterium lactisSD-Bi07-US
Bifidobacterium breveSD-BR3-IT
Respiratory Health Blend º
Respiratory Health Blend º
Bifidobacterium breveSD-B632-IT
Ligilactobacillus salivariusSD-LS01-IT
Dermatological Health Blend º
Dermatological Health Blend º
Bifidobacterium lactisSD-CECT8145-SP
Bifidobacterium longumSD-CECT7347-SP
Lacticaseibacillus caseiSD-CECT9104-SP
Prebiotic MAOS Microbiota-Accessible Oligomeric Substrates™
Prebiotic MAOS Microbiota-Accessible Oligomeric Substrates™
Molecular weight profiled inulin and fructooligosaccharides from chicory root.
Other Ingredients
Other Ingredients
Glyceryl fatty acid esters (for microencapsulation of certain probiotic strains).
Bridges thefiber gap.
Fiber is one of the hardest nutrients to incorporate into a child's diet—it can also directly impact the health of the gut microbiome.
95% of children and adults in the US do not reach theirdaily recommended fiber intake.With 5 grams of fiber per serving, PDS-08® is a meaningful complement to a healthy diet.
Food
Serving size
1 medium w/skin
1 cup
10 cherries
1 medium
1/2 cup
1 clove
Fiber
3.7g
3.4g
1.3g
3.0g
2.3g
0.19g
Quantity to match PDS-08®
1.4 apples
1.5 cups
38 cherries
1.7 bananas
1.1 cups
26.3 cloves
1 medium
1/4 cup
1 cup
1 slice
3.0g
3.2g
3.5g
1.5g
1.7 sweet potatoes
0.4 cups
1.4 cups
1.4 cups

Sustainablydelivered, monthly.
Each component of our refill system is designed to protect PDS-08® and be gentler on our Earth.

Month 1 — Welcome Kit
Biofilm Sachets (30-day supply) Aluminum BacTrac™ container

Month 2 — Sustainable Refills
Biofilm Sachets (30-day supply)

Strains that work harder for your whole body.
Chosen for their ability to improve gut function and build whole body health.
Gut + Immune Health Blend
Gut + Immune Health Blend
Probiotic blend for digestive health, gut barrier integrity, and healthy immune response.
Supporting strains:
Bifidobacterium breveSD-BR3IT.
Ligilactobacillus salivariusSD-LS1-IT Bifidobacterium longumSD-BB536-JP
Skin Health Blend
Skin Health Blend
Probiotic blend that improves clarity, texture, and signs of aging in 12 weeks.
Supporting strains:
Bifidobacterium longumSD-CECT7347-SP
Ligilactobacillus salivariusSD-LS1-IT
Heart Health Blend
Heart Health Blend
Supports healthy, balanced cholesterol levels.
Supporting strains:
Lactiplantibacillus plantarumSD-LPLDL-UK
Bifidobacterium lactisSD-MB2409-IT
































For Kids 3+
Whole body healthfor kids and teens.
PDS-08 Pediatric Daily Synbiotic is a clinically studied 2-in-1powdered synbiotic,formulated for ages 3-17 with 9 probioticstrains and a fiber-based prebiotic.
A new standardin probiotics.
Meet SciCare
Our team of experts in scientific communication and education—here for anyone and everyone in our community.
Pediatricians + Health Practitioners
Ask us about dosages, medication interactions, clinical research, and more.
Parents + Caregivers
Ask us anything—we know how hard making the right decisions can be on a minute-by-minute basis.

For the curious.
How should a child take PDS-08®?
How should a child take PDS-08®?
Pick a time of day to start PDS-08® with your child—you know your child’s routine best. It may be easiest to coincide with a mealtime (and it’s optimal to consume PDS-08® with food).
Take 1 sachet from your BacTrac™ container and pour it into a cold or room-temperature food or drink (Not hot, please.)
Mix well. Stir into food until fully mixed. If stirring into a drink, shake thoroughly in a closed bottle. Bacteria are fragile, so please no heat, blenders, or food processors, as these can impact the viability of the probiotics.
Enjoy within 30 minutes. Yes, this means all of it! As the probiotics and prebiotics are exposed to moisture, they activate and start to interact with one another. If left to sit for too long, this could lead to digestive discomfort after consumption.
Align the top of your BacTrac™ container with the day that you are starting. PDS-08® doesn't require refrigeration, so feel free to store it on your countertop.
Repeat and track so you never miss a day.
When will they feel something?
When will they feel something?
Every individual’s body is different, and the benefits one may “feel” (e.g. ease of bloating or easy, frequent poops) are often just the most visceral ones.
One may feel results in as little as 24—48 hours due to localized digestive support, though other longer-term benefits for gut-immune function or respiratory health may take longer, or may not be tangibly noticeable, which is normal. As long as daily intake is continued, PDS-08® is doing the work inside to program, sustain, and enhance your child’s health.
Is it safe?
Is it safe?
PDS-08® is generally safe to take and there are no known contraindications to use. Our probiotic strains have GRAS and/or QPS status, which designates them as safe for consumption by the United States and European Union, respectively. That said, we would also suggest consulting with a physician or pediatrician before adding any new product to a child’s regimen.
Can they take this with other medications?
Can they take this with other medications?
There are no known contraindications with PDS-08® Pediatric Daily Synbiotic and medications, therefore PDS-08® would be generally safe to take alongside any prescription or over-the-counter medications. However, we always recommend consulting with your doctor or family physician so they may advise with the complete knowledge of your child's health history.
Is PDS-08® compatible with my child’s diet or dietary restrictions?
Is PDS-08® compatible with my child’s diet or dietary restrictions?
PDS-08® Pediatric Daily Synbiotic adheres to a vegan and vegetarian diet and is rigorously monitored for 14 classes of allergens and over 20 total allergens as defined by the European Food and Safety Authority (EFSA), including dairy, gluten, soy, corn, sesame seeds, and nuts (almond, brazil, cashew, hazelnut, macadamia, peanut, pecan, pine, pistachio, and walnut)
Additionally, PDS-08® is preservative-free, Prop 65 compliant, does not contain added sugar, and is rigorously tested for glyphosate, AMPA, and over 500 other pesticides
What does my subscription include?
What does my subscription include?
Your monthly subscription includes a 30-day supply of PDS-08®, each dose housed in biofilm sachets. Your first month’s shipment is your Welcome Kit. It includes a refillable aluminum BacTrac™ container holding the first month’s supply of PDS-08® as well as some reading materials.
Each month, you will receive a 30-day supply of PDS-08®, which you can store in your refillable BacTrac™.
Is climate change real?
Is climate change real?
Yes.